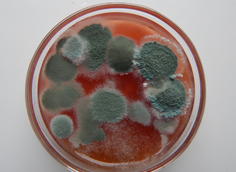

발톱 무좀 없애는 방법
- 카테고리 없음
- 2023. 11. 18. 22:44
발톱 무좀 없애는 방법 등 발톱 무좀에 관해 정리해드리도록 하겠습니다. 발톱 무좀은 발톱이나 손톱에 곰팡이가 감염되어 발톱이 변색되거나 두꺼워지는 질환입니다. 발톱 무좀은 보통 무해하지만, 통증이나 염증을 유발하거나 심한 경우에는 발톱이 떨어지는 등의 합병증을 일으킬 수 있습니다.
발톱 무좀 정보
발톱 무좀 증상






- 발톱이 하얗거나 노란색이 도는 반점이나 줄무늬를 띕니다.
- 발톱 색이 진하게 (갈색, 회색) 변하고 두꺼워집니다.
- 발톱이 일그러지거나 거칠어집니다.
- 발톱이 잘 빠지거나 끝이 부서집니다.
- 발톱에 하얀 가루가 잘 생깁니다.
발톱 무좀 원인

발톱 무좀은 다음과 같은 원인으로 생길 수 있습니다.
- 고온다습한 환경에 발을 오래 노출하는 경우
- 무좀 환자와 같은 신발, 슬리퍼, 수건 등을 사용하는 경우
- 목욕탕, 수영장, 사우나 등의 공용 시설을 이용하는 경우
- 당뇨병, 혈액순환 장애, 면역계 장애 등의 기저 질환을 가진 경우
발톱 무좀 없애는 방법



발톱 무좀은 조기에 치료하지 않으면 심각해질 수 있으므로, 증상을 발견하면 즉시 의사를 찾아야 합니다. 의사는 발톱을 검사하고 감염된 부분을 채취하여 어떤 진균이 원인인지 확인합니다. 그 후에 다음과 같은 치료 방법을 권할 수 있습니다.
- 항진균제: 구강용 약물이나 바르는 약물로 진균을 제거하는 방법입니다. 구강용 약물은 효과가 좋지만 부작용이 있을 수 있으므로 의사의 지시에 따라 복용해야 합니다. 바르는 약물은 부작용이 적지만 효과가 느릴 수 있습니다. 보통 3개월에서 1년 정도 치료 기간이 소요됩니다.
- 발톱 제거: 약물 치료가 효과가 없거나 감염이 심한 경우에는 발톱을 제거하는 수술을 받을 수 있습니다. 수술 후에는 새로운 발톱이 자라나기까지 몇 달이 걸릴 수 있습니다.
- 레이저 치료: 레이저를 사용하여 진균을 죽이고 발톱을 회복시키는 방법입니다. 비교적 새로운 치료 방법이며, 안전하고 효과적이라고 알려져 있습니다. 하지만 비용이 비싸고 보험에서 보상해주지 않을 수 있습니다.
발톱 무좀이 생기지 않으려면?



발톱 무좀을 예방하려면 발 위생을 잘 유지하는 것이 중요합니다. 다음과 같은 방법을 따라보세요.
- 발가락 사이의 공간에 주의하면서 발을 정기적으로 씻고 말리십시오.
- 통풍이 잘되고 너무 꽉 끼지 않는 신발을 선택하세요. 가죽이나 메쉬와 같은 통기성 소재는 곰팡이 발생 위험을 줄이는 데 도움이 될 수 있습니다.
- 양말은 매일 갈아입으세요. 가능하면 면이나 울과 같은 천연 소재의 양말을 착용하세요.
- 습한 장소를 맨발로 다니지 마세요. 공용 샤워실이나 수영장에서는 슬리퍼를 신으세요.
- 다른 사람과 발톱 클리퍼나 네일샵 용품을 공유하지 마세요. 개인용 클리퍼를 사용하고, 네일샵에서는 위생 상태를 확인하세요.
- 발톱을 너무 길게 자르지 마세요. 적절한 길이를 유지하면 감염 위험을 줄일 수 있습니다.
- 당뇨병이나 혈액 순환 장애와 같은 기저 질환을 잘 관리하세요. 면역력을 강화하기 위해 균형 잡힌 식사와 운동, 스트레스 관리를 하세요
체내 면역력을 높이는 방법
체내 면역력을 높이는 방법 등 정보에 대해 알아보도록 하겠습니다.면역력은 몸이 바이러스, 세균, 악성 종양 등의 병원체와 싸우는 능력을 말합니다. 면역력은 체내의 면역세포들이 일종의 방
healthfit.moa9.com
발톱 무좀은 예방이 가능한 질환입니다. 적극적인 예방과 관리를 통해, 발톱 무좀을 예방할 수 있습니다. 예방책을 유지하면, 발톱 무좀에 대한 불안감을 덜 수 있으며, 발가락을 건강하게 유지할 수 있습니다.
이상으로 발톱 무좀에 대한 정보를 알아보았으며 아래는 다른 정보 함께 두었으니 참고 하시길 바랍니다.